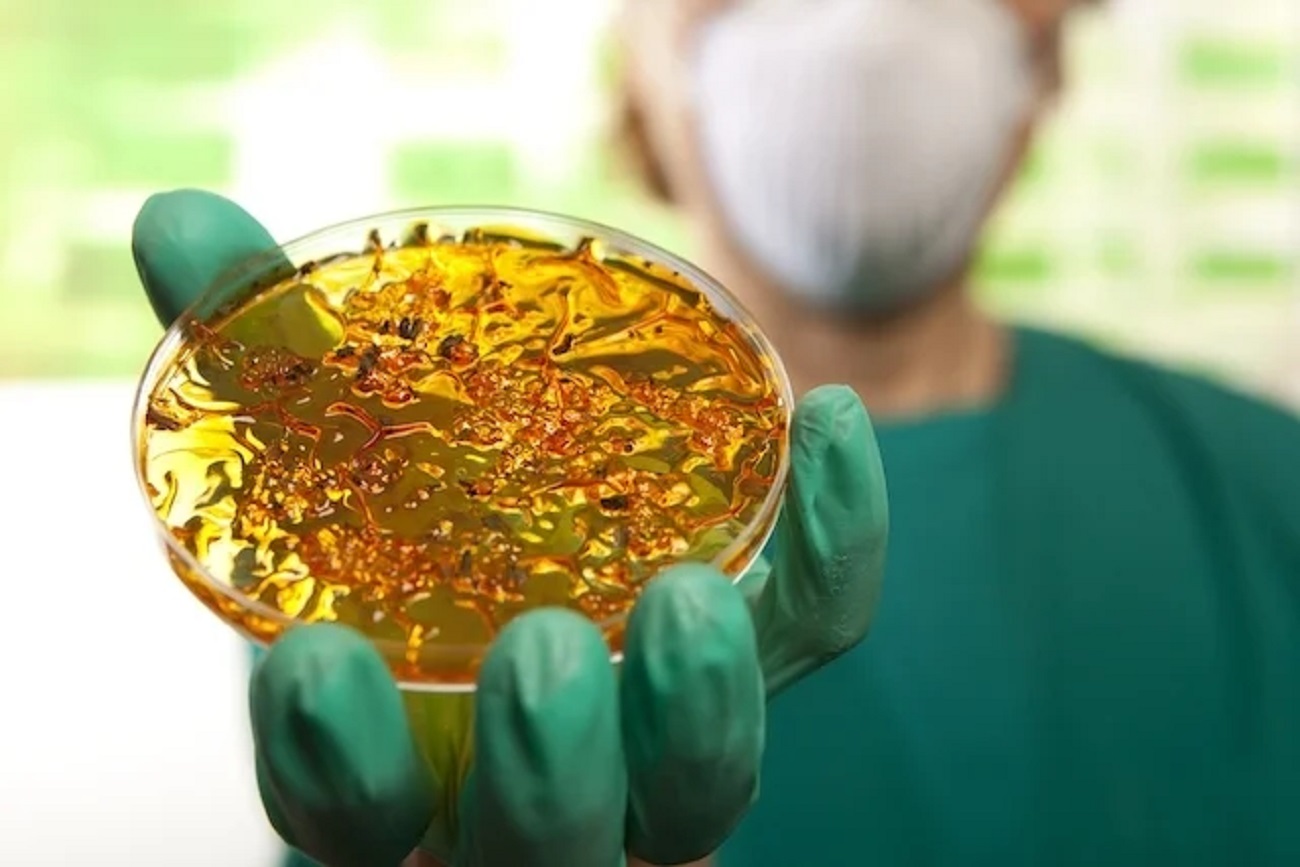

O Ministério da Saúde confirmou nesta sexta-feira (19) um caso autóctone de cólera em Salvador, o que significa que o paciente contraiu a doença na própria cidade, sem viajar a outro lugar.

Em nota, a Secretaria de Vigilância em Saúde e Ambiente informa que o caso foi detectado em um homem de 60 anos de idade que apresentou um desconforto abdominal e diarreia aquosa, em março de 2024. Duas semanas antes ele havia feito uso de antibiótico para tratamento de outra patologia. Segundo exames laboratoriais, a bactéria causadora da doença foi Vibrio cholerae O1 Ogawa.
Ainda de acordo com o Ministério da Saúde, trata-se de um caso isolado, tendo em vista que não foram identificados outros registros, após a investigação epidemiológica realizada pelas equipes de saúde locais junto às pessoas que tiveram contato com o paciente.
O período de transmissão da doença é de um a dez dias após a infecção. Entretanto, para as investigações epidemiológicas, no Brasil, está padronizado o período de até 20 dias por margem de segurança
Dessa forma, segundo a pasta, o paciente não transmite mais o agente etiológico desde o dia 10 de abril.
Últimos casos
No Brasil, os últimos casos autóctones de cólera ocorreram em Pernambuco nos anos de 2004 e 2005, com 21 e cinco casos confirmados, respectivamente. A partir de 2006, não houve casos de cólera autóctones, apenas importados, sendo um de Angola, notificado no Distrito Federal (2006); um proveniente da República Dominicana, em São Paulo (2011); um de Moçambique, no Rio Grande do Sul (2016); e um da Índia, no Rio Grande do Norte (2018).
De acordo com a Organização Mundial da Saúde (OMS), de janeiro a março de 2024, 31 países registraram casos ou declararam surto de cólera. Seguindo a classificação da OMS, a região africana foi a mais afetada, com 18 países. Nas Américas há surtos declarados apenas no Haiti e na República Dominicana.
Diante do cenário de casos de cólera no mundo, o Ministério da Saúde destaca a necessidade de os profissionais de saúde estarem sensibilizados quanto à situação epidemiológica da doença, à detecção de casos, à investigação epidemiológica e às medidas de prevenção e controle.
Doença
A cólera é uma doença infecciosa intestinal aguda, transmitida por contaminação fecal-oral direta ou ingestão de água e alimentos contaminados.
A maioria das pessoas infectadas permanece assintomática (aproximadamente 75%) e, daquelas que desenvolvem a doença, a maioria apresenta sintomas leves ou moderados, e apenas de 10% a 20% desenvolvem a forma severa, que, se não for tratada prontamente, pode levar a graves complicações e ao óbito.